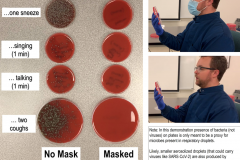

استفاده از سیر خام روی پوست میتواند به تحریک و حتی سوختگیهای شیمیایی منجر شود که زخمهای التهابی را به جا میگذارند
ماسک صورت
از زمان سر کار آمدن بایدن، مقررات مربوط به ماسک در آمریکا تشدید شده است
این هنرپیشه آمریکایی میگوید نمیتوان سادهلوحانه با ویروس کرونا برخورد کرد.